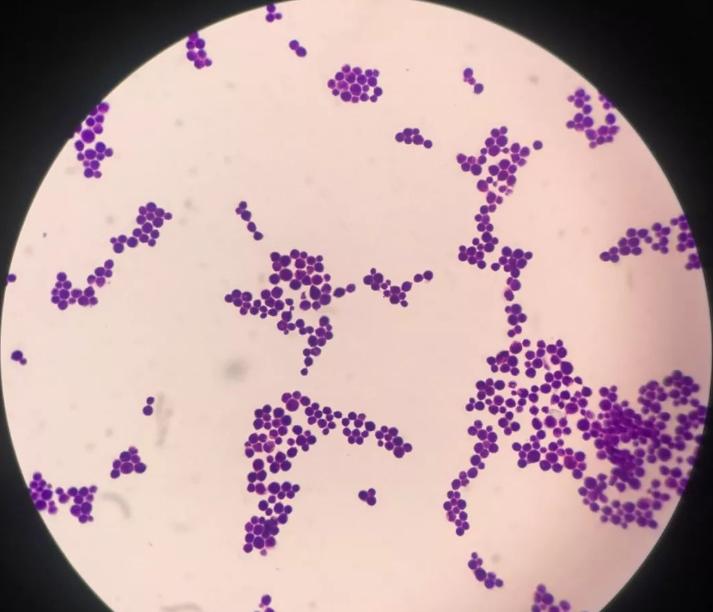
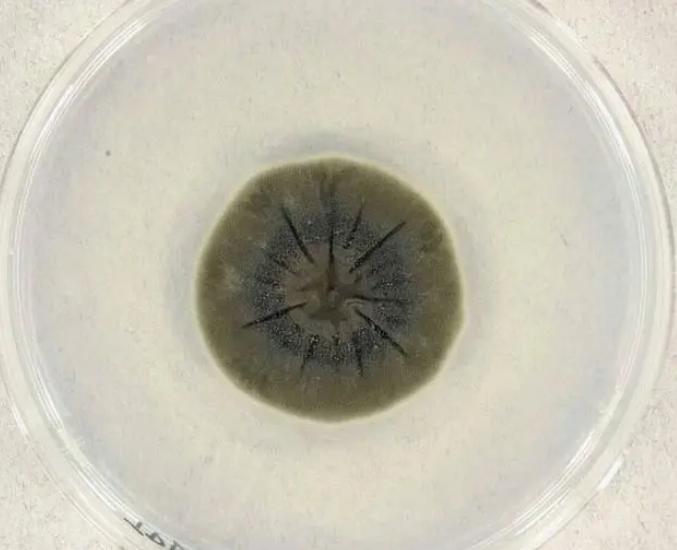

切爾諾貝利曾發現真菌,“吞輻射”繁殖,是否能成爲航天黑科技?
1986年4月26日的凌晨,切爾諾貝利核電站處一聲巨響,驚動了當地的居民,一瞬間火光沖天,大家紛紛上前圍觀。

【切爾諾貝利核電站】
起初,人們饒有興趣的在“看戲”,認爲這僅僅是一場平平無奇的火災,卻沒想到在日後演變爲了人類史上最慘痛的災難之一。
此後,切爾諾貝利核電站爲中心的方圓30公里範圍成爲了人類的禁區,根據科學家預測,其影響將維持10萬年之久!
從某種意義上來說,切爾諾貝利核電站事故也爲科學實驗提供了寶貴的數據。
比如說,在此次悲劇發生的幾年後,科學家通過科技手段,對切爾諾貝利核電站遺址進行了探查。他們在發生事故的4號核反應堆牆壁上,發現了大面積的黑色物質。

【牆壁上的黑色物質】
通過進一步檢驗,科學家得出結論,這是一種黑色真菌,它靠“吞輻射”繁衍,這種另類“生命”的發現,也讓科學家們有了些特別的靈感。
事故帶來的持久影響
事實上,雖然在切爾諾貝利核電站事故發生之後,這裏變成爲了人類的禁區,但是仍舊時常會有動物生活在其中。
這些動物受到核輻射的影響,基因方面出現了不同程度上的變異,並且呈現出和父代完全不同的情況。

這些動物有的能夠在輻射當中頑強生活下來,是科學家們研究輻射對生物影響的重要生物體之一。
再加上災難發生之後,由於蘇聯官方對切爾諾貝利核電站長期管控的必要性,因此蘇聯每隔一段時間就會派機器人進入到其中收集樣本,查看情況。
讓人意外的是,這個人類的禁區似乎成爲了變異動物們的天堂,在這裏可以偶爾看到狼、麋鹿等動物。
隨着機器人的深入,科學家們發現,在發生事故的4號核反應堆牆壁上,甚至是核反應堆的冷卻水當中,竟然長着黑色的真菌。

【核反應堆】
一般來說,越是接近切爾諾貝利核電站的中心,其核輻射值也就越高,反應堆附近的輻射值高得嚇人,可以達到數萬倫琴。
這是什麼概念呢?就這麼說吧,如果一個人不穿防輻射服直接站在這樣的環境當中,可能會直接化爲一灘血水。
要知道,當初切爾諾貝利核電站首次發生大爆炸時,產生的輻射劑量已經達到了廣島原子彈的400倍以上,這還沒有算上後續的輻射泄漏。

在這樣的環境當中,幾乎不可能存在任何生物。
神祕真菌
在發現這種黑色真菌之後,科學家指揮機器人將其小心翼翼的採集起來,並做好多種安全工作之後,打包送到實驗室。
經過研究發現,這種真菌屬於變異之後的新型隱球菌,並非真正意義上的新品種。
因爲它早在近代就被科學家發現,並且它還是爲數不多能夠致病的真菌。
新型隱球菌主要針對人類神經系統進行侵蝕,嚴重的情況可能會導致患者死亡。
【顯微鏡下的新型隱球菌】
像鴿子糞便當中,就有可能含有新型隱球菌,但量比較少,只要不是大規模聚集,就不會導致疾病。
而此次在切爾諾貝利發現的變異新型隱球菌極爲特殊,它的顏色相比科學家此前發現的同類真菌更深。
最爲關鍵的一點是,在切爾諾貝利中心是不含有可供給真菌生長的有機物質的,並且機器人發現它的地方,恰好有着大量核輻射,這說明變異新型隱球菌極有可能對核輻射有極強的抵抗力,甚至“吞輻射”繁殖。
這就令人匪夷所思了,所謂核輻射是指放射性物質以波或者微粒的形式發出的能量,一般來說是不具備滋養生物功能的。

然而,這裏的變異新型隱球菌極爲特殊,充分說明了我們對生物的認知也許還不夠全面。
未來或有大用處
但不管怎麼說,科學家們對變異新型隱球菌進行相對細緻的研究後,認爲其可能靠“吞輻射”繁衍的特性,說不定在未來能成爲解決令人頭疼的核輻射問題的關鍵。
並且也能衍生成爲一種航天黑科技,幫助人類進行範圍更廣、更加細緻的太空探索。
要知道,在深邃的外太空,含有數不清的各類輻射。

【浩瀚的宇宙隱藏了太多未知】
雖然宇航員有專門的宇航服作爲保護,但是如果長時間暴露在宇宙環境當中,宇航服也不能完全發揮作用。
更何況,宇宙的各種人類還未認知的輻射或許存在,現有的宇航服究竟能否發揮多大的作用還很難說。
再者,現在的太陽系其實是比較安全的,太陽風在太陽系的邊緣形成了一道天然屏障,抵擋了來自宇宙之外的大部分有害射線。
人類總有走出太陽系的一天,但迄今爲止我們似乎並沒有能夠應對未知宇宙危害的手段。

如果說,未來能夠將變異新型隱球菌運用到新型的宇航服當中,是否能夠在一定程度上起到隔絕輻射的作用呢?
這種構想聽上去簡單,實際施行起來是非常困難的,畢竟人類對於核輻射的相關研究並不算多,再加上宇宙中的各類輻射多種多樣,這就爲變異新型隱球菌在航天領域的運用增添了巨大的不確定性。
還有一點,既然變異新型隱球菌能夠抵抗核輻射,那麼我們是否在未來的核反應堆的建造當中,增加這種物質來保持反應堆的持續穩定性?
甚至我們還可以向更遠的未來構想,現在的核反應堆受制於技術和材料的限制,很難運用在航天領域。
未來我們是否可以依託變異新型隱球菌爲材料,打造一款核動力運載火箭,甚至是宇宙飛船呢?

【總有一天夢想會照進現實】
種種新奇的構想指引着人類未來的發展方向,也許不是現在,但至少我們可以嘗試。
參考資料:
【1】中華人民共和國商務部:《切爾諾貝利核泄漏事故影響深遠》
【2】肖傑生,王飛. 中樞神經系統新生隱球菌病54例臨牀分析和探討.《廣東醫學》

















